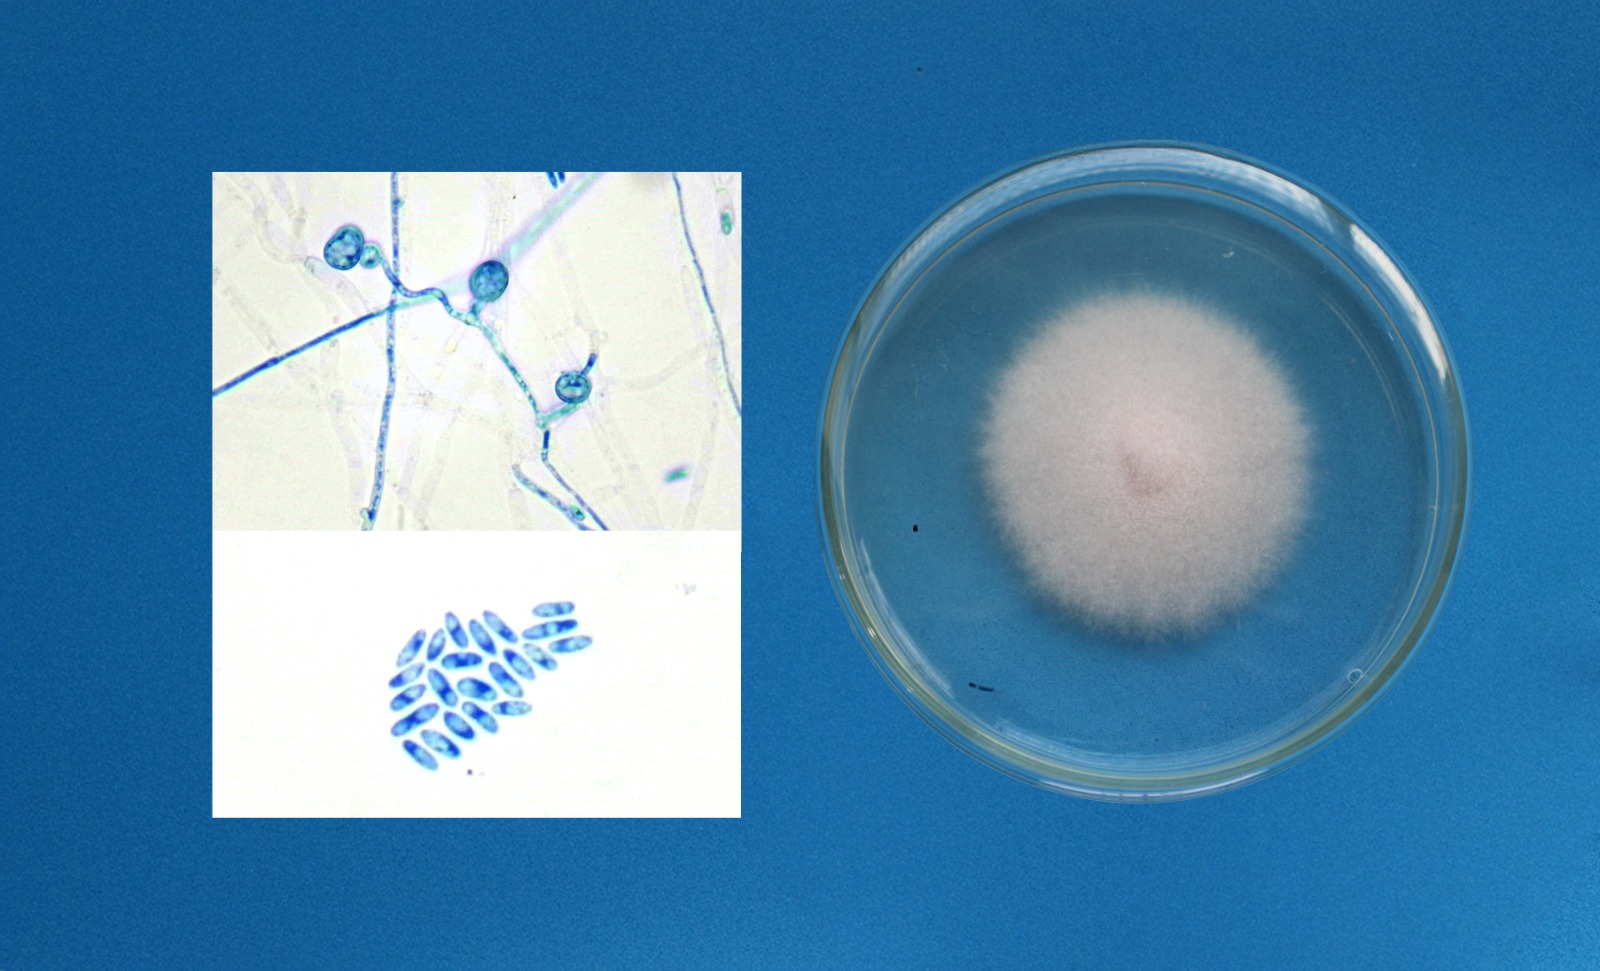

Descoberta inédita é fruto de pesquisa apoiada pela FAPEMA e foi publicada em revista internacional
Leonardo de Oliveira
Doutor e mestre em Agroecologia pela Universidade Estadual do Maranhão (UEMA), onde se graduou em Agronomia. Experiência na área de Agronomia, atuando principalmente em pesquisas sobre agricultura orgânica, controle alternativo e biológico de doenças de plantas com ênfase em Fusariose, olericultura, taxonomia de fungos, genética de fungos e plantas e sanidade de sementes
Fungo prejudicial à produção de coentro – conhecido como cheiro verde – em áreas agrícolas do Maranhão, foi identificado pela primeira vez no Brasil. A descoberta inédita é resultado de pesquisa conduzida pelo agrônomo da Universidade Estadual do Maranhão (UEMA), Leonardo de Jesus Machado Gois de Oliveira, e revelou que o fungo pode comprometer até 70% destas plantações. A pesquisa abre caminho para novos métodos de controle no cultivo do coentro e na orientação de produtores para uma cultura mais eficaz. O projeto terá continuidade para avaliação de mais impactos e melhor conhecimento deste patógeno.
Intitulada ‘Primeiro relato de Fusarium oxysporum f. sp. coriandrii causando Murcha de Fusarium em Coentro no Brasil’, a pesquisa foi desenvolvida com apoio da Fundação de Amparo à Pesquisa e ao Desenvolvimento Científico e Tecnológico do Maranhão (FAPEMA e publicada na revista científica internacional Plant Disease. O estudo foi realizado no Laboratório de Fitopatologia da UEMA, sob coordenação da professora Antonia Alice Costa Rodrigues, integrando o Programa de Pós-Graduação em Ciências Agrárias. O grupo atua no apoio a agricultores familiares, realizando diagnósticos e buscando soluções para controle de doenças em plantas.
Para confirmar a presença do Fusarium oxysporum f. sp. coriandrii, foram realizados testes de identificação morfológica, molecular e de patogenicidade. Amostras foram cultivadas em laboratório e analisadas sob microscópio, com observação de estruturas como hifas e conídios. Também foram extraídas sequências de DNA de três regiões genéticas (IGS, ITS e TEF 1α) que, ao serem comparadas com dados internacionais do Genbank, confirmaram o ineditismo do registro no Brasil. O GenBank é um banco de dados público e gratuito, mantido pelo National Institutes of Health (NIH), que contém todas as sequências de DNA disponíveis publicamente.
Segundo Leonardo de Oliveira, o problema já havia sido detectado na cultura do coentro e motivou o aprofundamento da investigação. Ele conta que, com o avanço das pesquisas, veio a necessidade de solucionar esse problema que se tornou foco da sua tese de doutorado. O fungo foi encontrado inicialmente em áreas de cultivo de coentro em São Luís e, posteriormente, em Formosa da Serra Negra.
A doença atinge plantas entre 20 e 25 dias de idade, causando clorose, murcha e morte das plantas, especialmente das cultivares Verdão e Verdão Super. Os testes de patogenicidade demonstraram alta taxa de infecção, reforçando a gravidade do problema para os produtores locais. A identificação correta do patógeno é importante para promoção de estratégias de controle mais eficazes.
“Esse resultado amplia o conhecimento taxonômico e ecológico da doença, além de fornecer informações práticas para o manejo no campo. A presença desse fungo em diferentes municípios é uma informação nova e muito relevante para os produtores maranhenses”, ressalta o pesquisador Leonardo de Oliveira.
A FAPEMA garantiu financiamento para aquisição de reagentes e equipamentos necessários para a identificação do patógeno. O pesquisador parabeniza “o compromisso da instituição com a pesquisa aplicada, voltada aos problemas locais e à melhoria da vida dos maranhenses, a exemplo deste trabalho que desenvolvemos e cujo apoio foi de suma importância”.
O trabalho terá continuidade com novas frentes de investigação. Entre elas, o teste de sanidade de sementes (Blotter Test) para avaliar se o fungo pode ser transmitido via sementes, e ensaios com controle biológico utilizando bactérias do gênero Bacillus associadas ao Trichoderma. Também está prevista a avaliação de diferentes cultivares, a fim de identificar genes de resistência ao fungo.
A descoberta é um avanço importante para a agricultura maranhense e pode ter impacto nacional no manejo do coentro, uma das hortaliças mais consumidas do Brasil. O trabalho também aponta os resultados positivos dos investimentos em ciência e na valorização de pesquisas voltadas às realidades locais.